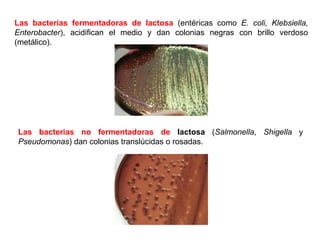
Las bacterias no fermentadoras de lactosa (Salmonella, Shigella y
Pseudomonas) dan colonias translúcidas o rosadas.
Las bacterias fermentadoras de lactosa (entéricas como E. coli, Klebsiella,
Enterobacter), acidifican el medio y dan colonias negras con brillo verdoso
(metálico).
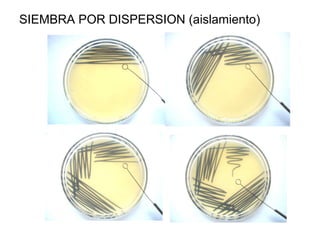
SIEMBRA POR DISPERSION (aislamiento)
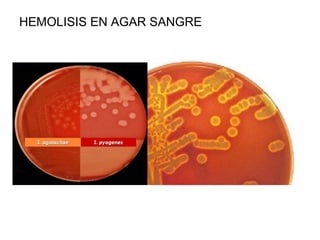
HEMOLISIS EN AGAR SANGRE
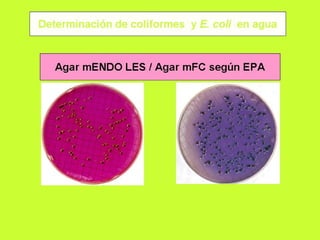
Cultivo bacteriano 2005..
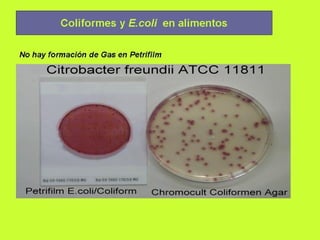
Cultivo bacteriano 2005..

Este documento describe los macronutrientes y micronutrientes necesarios para el crecimiento de los microorganismos, así como los diferentes tipos y clasificaciones de los medios de cultivo, incluyendo su composición, estado y uso para el aislamiento y cultivo de microorganismos. También explica los procedimientos de siembra por dispersión y agotamiento para cultivar microorganismos de manera aislada.